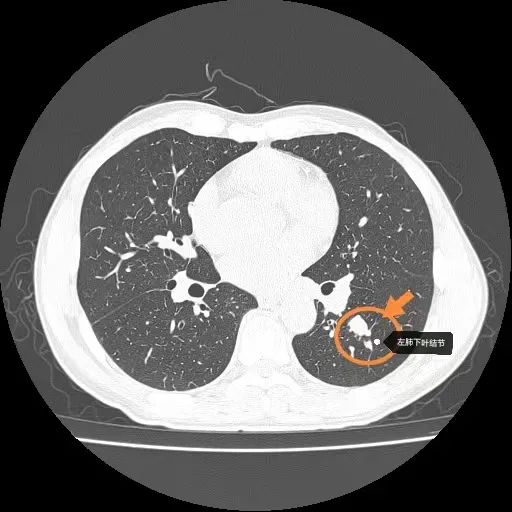

病例概要
患者,中年男性,主因“发现左肺下叶结节伴肺门淋巴肿大1周”来诊,由门诊以“肺部占位性质待查”收入清华大学附属垂杨柳医院胸外科。入院后完善各项检查后,行经支气管超声引导纵隔淋巴结针吸活检术(EBUS-TBNA),冰冻病理考虑恶性肿瘤,具体结果待石蜡。患者术后第一天出现头晕、恶心呕吐,症状持续不缓解。给予对症止吐治疗,症状改善不明显。追问患者既往1月前曾有类似症状,可自行缓解。遂请神经内科、骨科及耳鼻喉科会诊,除外颅内病变、颈椎病及耳石症等相关疾病。患者血化验检查显示血钠118mmol/L,给予静脉及口服补钠后症状缓解。患者石蜡病理回报考虑纵隔转移性小细胞肺癌。结合病史考虑左肺下叶小细胞肺癌伴纵隔淋巴结转移,低钠血症为抗利尿激素分泌失调综合征。
胸部CT
左肺下叶结节

左肺门淋巴结
什么是SIADH?
SIADH的临床表现主要与抗利尿激素分泌失调综合征(syndrome of inappropriate secretion of antidiuretic hormone,SIADH)是指由于多种原因引起的内源性抗利尿激素(ADH)分泌异常增多,从而导致水潴留、尿排钠增多以及稀释性低钠血症等有关临床表现的一组综合征。50%~70%的SIADH患者的病因是肿瘤,其中最常见的是小细胞肺癌[1]。小细胞肺癌常伴有神经内分泌,可合成和分泌异源类抗利尿激素多肽,且不受正常调节机制控制而自主释放[2]。它们对抗利尿激素(ADH),即精氨酸加压素(AVP)产生作用,使AVP分泌异常增多或活性超常[2]。低钠的严重程度及起病缓急有关。常表现为四肢无力、乏力、厌食、头晕、恶心、呕吐等,严重者可出现意识障碍、昏迷等神经系统症状[3]。
SIADH的诊段方法
SIADH的诊断[4]在中枢神经系统疾病、恶性肿瘤和肺部疾病等基础上,出现:1)血钠低于135mmol/L;2)血浆渗透压<275mOsm/kg;3)尿渗透压>100mOsm/kg;4)血容量正常;5)正常摄入盐时尿钠浓度升高>30mmol/L;6)肾脏、甲状腺功能及肾上腺功能正常。
SIADH的治疗:1、病因治疗:在诊断明确后尽快进行肿瘤相关治疗,在原发病得到控制后,患者低钠血症得到就诊,症状会得到缓解。2、对症治疗:包括限制液体、使用高渗盐水、袢利尿剂、口服钠、尿素、加压素V2受体拮抗剂(托伐普坦)等[5, 6]。
参考文献
[1] Gustafsson B I, Kidd M, Chan A, et al. Bronchopulmonary neuroendocrine tumors[J]. Cancer, 2008,113(1):5-21.
[2]魏子欣,孟庆威,于雁.癌症患者低钠血症治疗研究进展[J].肿瘤研究与临床, 2018,30(10):707-710.
[3]孙萍萍,王旭.小细胞肺癌合并抗利尿激素分泌异常综合征的研究进展[J].中国肿瘤临床, 2017,44(5):233-237.
[4] Berardi R, Rinaldi S, Caramanti M, et al. Hyponatremia in cancer patients: Time for a new approach[J]. Crit Rev Oncol Hematol, 2016,102:15-25.
[5] Verbalis J G, Goldsmith S R, Greenberg A, et al. Diagnosis, evaluation, and treatment of hyponatremia: expert panel recommendations[J]. Am J Med, 2013,126(10 Suppl 1):S1-S42.
[6]谭光根,李静,刘丽.小细胞肺癌合并抗利尿激素分泌异常综合征研究进展[J].中国全科医学, 2013,16(27):3164-3167.
本文仅限于公益科普及学术交流,如有不适请及时就医。部分学术内容来源于文献资料,侵删。


